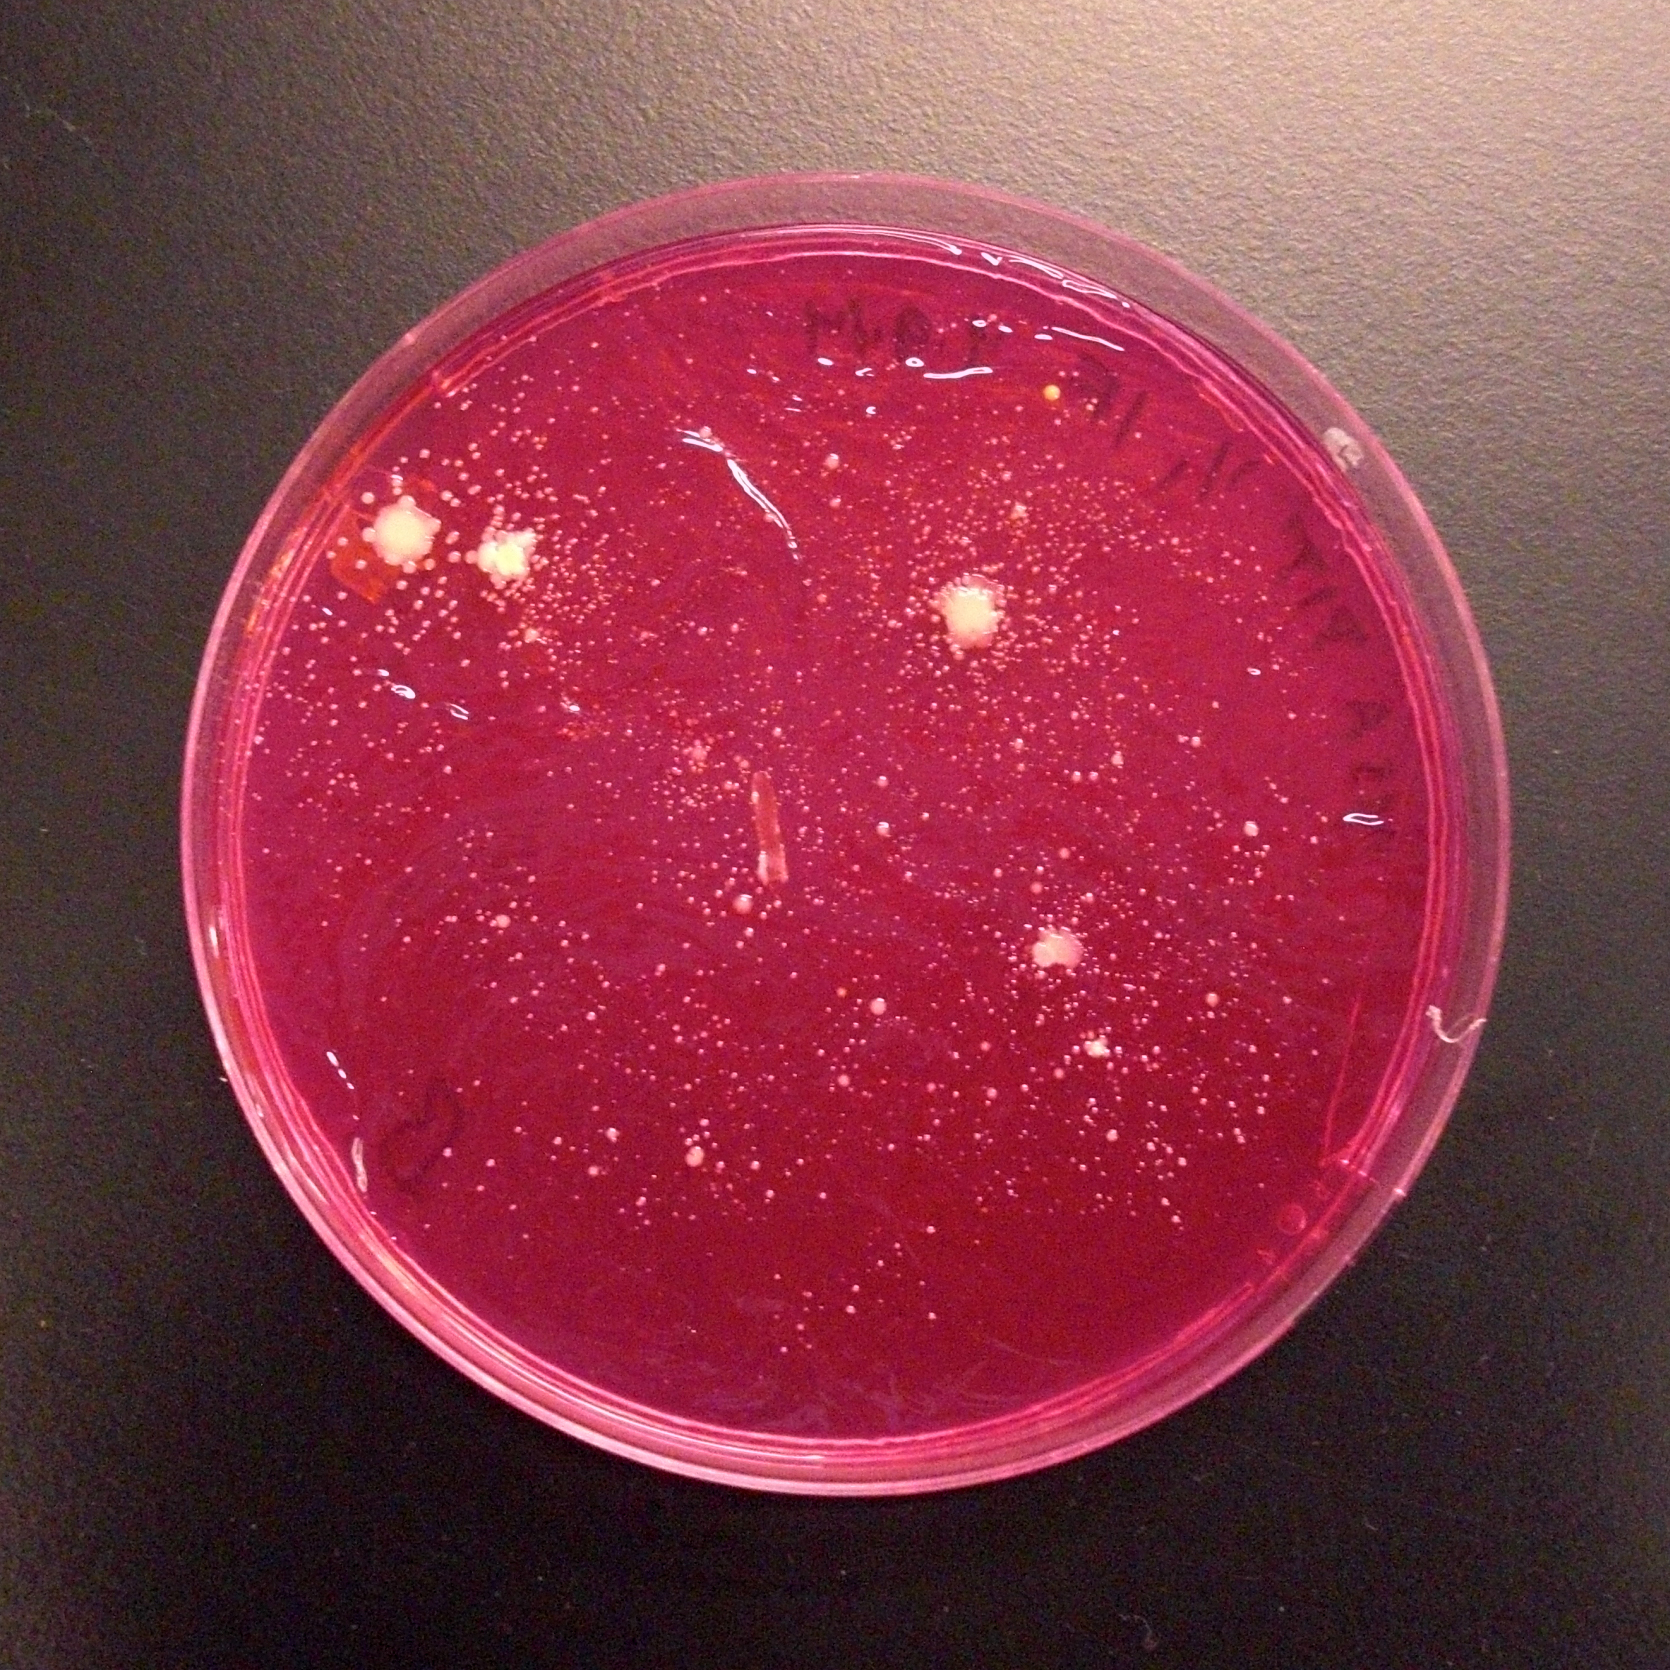

| Video Documentation |
Labor Paul Vanouse 2019 - ongoing |
Vanouse projects |

| What does labor smell like? Labor is
a dynamic, self-regulating art installation that re-creates the scent of people exerting
themselves under stressful conditions. There are, however, no people
involved in making the smell – it is created by bacteria propagating in
the three glass bioreactors. Each bioreactor incubates a unique species
of human skin bacteria responsible for the primary scent of sweating
bodies: Staphylococcus epidermidis, Corynebacterium xerosis and Propionibacterium avidum.
As these bacteria metabolize simple sugars and fats, they create the
distinct smells associated with human exertion, stress and
anxiety. Their scents combine in the central chamber with which a
sweatshop icon, the white t-shirt, is infused as the scents are
disseminated. The scent intensifies throughout
the exhibition. (photo above, Francesca Bond/Buffalo News) |
 |
The Labor
project reflects upon industrial society’s shift from human and machine
labor to increasingly pervasive forms of microbial manufacturing.
Today, microbes produce a wide range of products, including enzymes,
foods, beverages, feedstocks, fuels and pharmaceuticals. They literally
live to work. These new industrial activities point to a deepening of
the exploitation of life and living processes: the design, engineering,
management and commodification of life itself. In Labor, the
microorganisms ironically produce the scent of sweat, not as a vulgar
bi-product of production, like in factories of the 19th and 20th
centuries, but as a nostalgic end-product. opposite: Labor, Burchfield Penny Art Center. photo by Tullis Johnson. |
| The
sweat-stain-transfer imprints are a novel analog documentation method.
Moist, freshly soiled shirts are dusted with charcoal and sandwiched
between paper at high pressures, which impregnates the paper surface
with their image. In the Buffalo exhibition, each
pair of prints chronicle a single t-shirt that was worn by a university
student paid at the prevailing wage. The images are full-scale,
two-dimensional records of a richly visual termporal moment and
unconscious performative action. Both front and back stains of each
t-shirt are rendered. This method was first demonstrated at Cultivamos Cultura in São Luis, Portugal in the summer of 2017. After heavy laboring, I collected our sweaty shirts, dusted them, sandwiched them between paper and boards, and ran them over with an SUV. This produces embossed evidence of labor, portraits not of people nor of shirts but patterns of intimate excretion. Subsequent imprints were demonstrated in the Labor performance at Applied Microperformativity symposium in Vienna, Austria in 2018. opposite: Martin, Front: seat-stain-transfer print, 2018. |
 |

|
Labor
also reflects upon our changing understanding of what we are. Microbes
in and on the human body vastly outnumber human cells and they help
regulate many of our bodily processes, from digestive and immune
systems to emotional and physiological responses like sweating. Our
microbiota is integral to who and what we are, and complicates any
simplistic sense of self. Likewise, the smell of the perspiring body is
not just a human scent, unless we are willing to redefine what we mean
by human. opposite: Bioreactor from Labor. Burchfield Penny Art Center. photo by Tullis Johnson. |
| Three bacterial
strains have been identified as keys to the production of human scent,
from the genera Staphylococcus, Propionibacterium and Corynebacterium.
Staphylococcus species metabolize skin secretions into compounds such
as isovaleric acid, to produce a fairly mild scent and are associated
with the eccrine sweat glands, which excrete primarily salts and water
to regulate body temperature. Humans’ ability to distinguish this
“high-pitched” scent has been found to vary by as much as one
hundred-fold between individuals. Propionibacterium species metabolize
more complex excretions from the apocrine glands and are responsible
for vinegary, acrid odors, particularly under anaerobic conditions.
Corynebacterium break down the lipids in sweat to create smaller
volatile molecules like butyric acid. However, all these microbes act
in complex, communalistic ways on the human body and utilize varied
metabolic pathways to produce an aromatic bouquet of a complexity far
greater than the sum of their parts. opposite: Petri dishes containnig first experimental isolation of Staph epidermidis from Vanouse's armpit on MSA medium, Biofilia, Aalto Univesity Helsinki, 2014. |
|
 |
I initiated Labor at the
Biofilia laboratory in Helsinki in 2014. There I
isolated Staph epidermidis, which produces a mild scent, and Propioni
bacteria, which produces funky, acrid odors. I isolated them by
covering my armpits in sterile pads in a day that included mild
exercise and white collar labor, replying to emails,
and scheduling meetings. This file details the steps undertaken in the project preproduction phase. Labor Preproduction steps pdf file Cultivating skin bacteria in vitro is difficult as these strains are best suited to the complex ecosystem of human skin. At the Coalesce lab, University of Buffalo, I’ve built custom incubation equipment to investigate at which metabolic stages, and under which conditions these organisms are most fragrant. I have not engineered genes into microbial production strains (as a synthetic biology approach would entail), but rather adjusted incubation conditions to fit the organisms and maximize their particular scents. The three custom bioreactors are monitored by a Raspberry Pi-based automation system that incorporates stirrers, biosensors, pumps, heaters and valves to automate these conditions for continuous production. Visitors to the installation are immersed in both the scent of the microbes as well as the sounds of these processes, such as nutrients and pressurized gasses flowing through the automation system and into the bioreactors. opposite: Developing Labor. Coalesce Center for Biological Art. |
| Thanks to: Scientific Collaborator: Solon Morse, University at Buffalo. Scientific Advisor: Jerry Koudelka, University at Buffalo. Fabrication: Tom Gruenauer, University at Buffalo. Special Thanks to: Don Metz, Scott Propeack, Tullis Johnson, Jennifer Surtees, Shanna Snider and Jeff Sherven without whom this exhibition would not have been possible. Additional Thanks to: Eileen Sylves, Kristie Reilly, Kevin Cullinan, Gary Nottingham, Domenic Licata, Sara Thomas, Dave, Pawlowski, Mizin Shin, Alyssa Crane, Leonardo Aranda Brito, Darya Warner, Robert Jones, John Santomieri, Martin Chittum, Fern Johansson, Goldie Segol, Orry Segol, University at Buffalo. John Malinowski, Tom Holt, Buffalo State College Marta De Menezes, Cultivamos Cultura, Portugal. Ulla Taipale, Pia Lindman, Marika Hellman, Aalto University, Finland. Jens Hauser, University of Copenhagen, Denmark. Supported by: Burchfield Penny Art Gallery, Buffalo State College. Coalesce Center for Biological Art; Genome Environment and Microbiome Community of Excellence; Humanities Institute; CAS Machine Shop; Department of Art at University at Buffalo. Angewandte Innovation Lab, University of Applied Arts, Vienna, Austria. Biofilia: Base for Biological Arts, Aalto University, Helsinki, Finland. HIAP Artist in Residence program, Helsinki, Finland. Cultivamos Cultura Artist in Residence program, São Luis, Portugal. And extra special thanks to: Joan Linder, Rafael Vanouse and Lucien Vanouse.  Winner of 2019 Prix Ars Electronica Golden Nica Award. |
 |